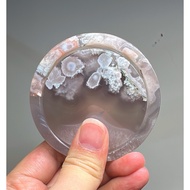
Cherry Blossom Agate Bracelet (60) Peach Cartier/Interesting Come And Watch Movies

$31.34 ~ $127.82
Shopee
lingying88888co.sg
Shopee
Shopee Majulah Club 💎👑 Smart Perks & Gold Privileges for Users Aged 50 and Above 🌿⭐$42.17 ~ $51.43
$21.00 ~ $25.60
$42.17 ~ $51.43
$24.53 ~ $45.67
$20.17
$153.15
$30.52 ~ $50.69
$79.46
$31.34 ~ $127.82
Shopee
lingying88888co.sg
$148.35 ~ $165.12
$31.34 ~ $127.82
Shopee
lingying88888co.sg

$24.53 ~ $45.67
「
cartier bracelet
」Related SearchesPrice range
-
Store filter
5 stores
Search settings
Hide sold-out items(10)
Hide spam

![[Pre-owned] Cartier Bracelet, 2C Diamond Bracelet, Wrist Size 17.5cm, K18 (Yellow Gold) / K18WG (Whi](https://img2.biggo.com/190x,svl2t-fAaTpWWDFCFOZT6_oBdCI9Gx8IoKK_YQid19UQ/https://image.dokodemo.world/skus/7930959/bc85246b4813305705b6f308d9bd6c0e.jpg)
![Cartier Lily of the Valley Bracelet, 18K Pink Gold, Approx. 3.87g, Women's [Pre-owned]](https://img2.biggo.com/190x,sFOInkAEbqSx_WvqPJdEs7xFLn5hSDB-zKKcBYqsrJuw/https://image.dokodemo.world/skus/7969531/12dc9254dbd9d451ba83326f9e781174.jpg)